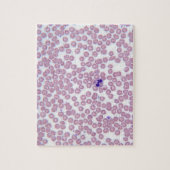
Malariële bloedcellen legpuzzel (Verticaal)

Over Puzzels
Aangeboden door
Over dit ontwerp
Malariële bloedcellen legpuzzel
Malariumhoudende bloedcellen | "Michael J. Klein, M.D." | AssetID: 142021985
Ontwerp van international designer
Klant beoordelingen
5.0 van 5 sterren beoordeling2 aantal beoordelingen
2 Reviews
Beoordelingen voor identieke producten
5 van 5 sterren beoordeling
Door J.23 mei 2020 • Geverifieerde aankoop
Puzzel, 27,9 x 35,5 cm, 252 stukjes
Zazzler recensent programma
De kwaliteit van het product was super. De levering was goed, alleen jammer dat het corona tijd was en daardoor duurde het iets meer dan 2 volle weken vooraleer het in de bus kwam. De afdruk was dik ok. Geen enkele negatieve opmerking.
Enkele dagen puzzelwerk. Plezante bezigheid.
5 van 5 sterren beoordeling
Door Jan G.7 januari 2024 • Geverifieerde aankoop
Zazzler recensent programma
Prima en leuk product. Prima en zeer mooi maar grotere fotoafdruk zou ideaal zijn voor puzzelaar.
Origineel product
Tags
Andere Info
Product ID: 116689754979453795
Ontworpen op: 29-10-2012 15:43
Rating: G
Recent bekeken items